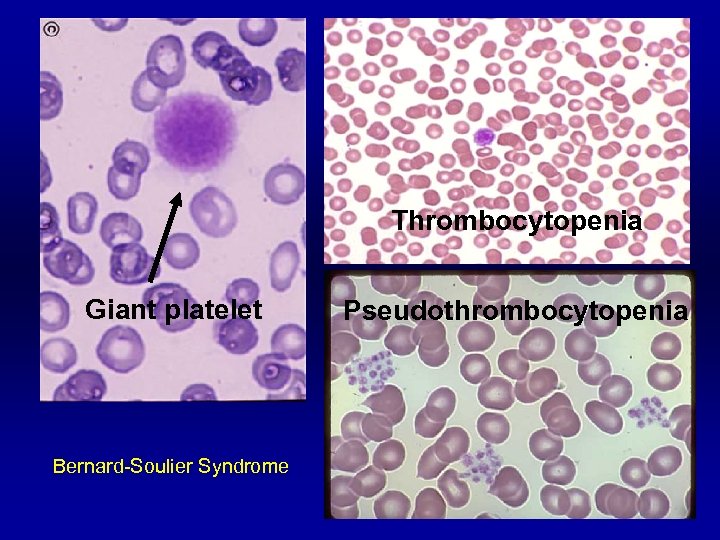
Thrombocytopenia Giant platelet Bernard-Soulier Syndrome Pseudothrombocytopenia

8321d93801848b58458bc2346bb0b602.ppt
- Количество слайдов: 111

Coagulopathy Bundarika Suwanawiboon M. D. Yingyong Chinthammitr M. D. Theera Ruchutrakool M. D. Division of Hematology Department of Medicine Faculty of medicine Siriraj Hospital Bangkok Thailand 10700

Coagulopathy Bundarika Suwanawiboon M. D. Yingyong Chinthammitr M. D. Theera Ruchutrakool M. D.

Coagulopathy Outline § Basic of Normal Hemostasis (35 minutes) § Clinical and Laboratory Approach to Theera Bundarika Bleeding Patients (35 minutes) § Management of Bleeding Patients Yingyong (35 minutes) §Question and answer(15 minutes) All

Normal Hemostasis Normal hemostasis § Blood vessel § Platelet § Coagulation factors § Fibrinolytic system § Natural anticoagulants

Red blood cell Platelet

Red blood cell Platelet

Red blood cell Platelet Von Willebrand factor

Red blood cell Platelet Von Willebrand factor

Red blood cell Platelet Von Willebrand factor

Red blood cell Platelet Von Willebrand factor

Red blood cell Platelet Von Willebrand factor

Red blood cell Platelet Von Willebrand factor

Red blood cell Platelet Von Willebrand factor

Red blood cell Platelet Von Willebrand factor

Red blood cell Platelet Von Willebrand factor

Red blood cell Platelet Von Willebrand factor Fibrin polymer

Red blood cell Platelet Von Willebrand factor Fibrin polymer

Red blood cell Platelet Von Willebrand factor Fibrin polymer

Normal Hemostasis Normal hemostasis § Blood vessel § Platelet § Coagulation factors § Fibrinolytic system § Natural anticoagulants

Normal Hemostasis Blood vessel § Endothelium § Connective tissue or collagen

Normal Hemostasis Blood vessel § Endothelium Thrombogenesis § von Willebrand factor § Tissue thromboplastin § Endothelin Antithrombotic Effect § Thrombomodulin § Platelet derived relaxing factor (PDRF) § Prostacyclin (PGI 2) § Tissue plasminogen activator

Normal Hemostasis Blood vessel § Endothelium § Connective tissue or collagen

Normal Hemostasis Blood vessel § Endothelium § Connective tissue or collagen § Collagen direct bind activate platelet § Release von Willebrand factor to bind platelet

Normal Hemostasis Platelet § Adhesion § via glycoprotein (GP) § Shape change § from disc to ameboid form § Release § ADP, thromboxane A 2, v. WF § Aggregation § via glycoprotein (GP)

Normal Hemostasis Platelet ligand § aggregation v. WF GP Ib/IX/V collagen § adhesion receptor GP Ia/IIa fibrinogen GP IIb/IIIa

Normal Hemostasis Platelet plug formation and vasoconstriction Primary hemostatic plug formation which is enough to stop bleeding from small and shallow wound

Normal Hemostasis Factor XII Coagulation HMWK/PK Factor XIa Factor IX Factor VIIa factor pathway Factor IXa Factor VIIIa Tissue Factor Xa Factor Va Prothrombin

Normal Hemostasis Factor XII HMWK/PK Factor XIa Factor IX Factor VIIa factor Extrinsic pathway Factor IXa Factor VIIIa Tissue Intrinsic pathway Factor Xa Factor Va Common pathway Thrombin Prothrombin

Normal Hemostasis Factor XII Coagulation HMWK/PK Factor XIa Factor IX Factor VIIa factor pathway Factor IXa Factor VIIIa Tissue Factor Xa Factor Va Prothrombin

Normal Hemostasis Factor XII Natural HMWK/PK Factor XIa Factor IX Factor VIIa factor Factor IXa Factor VIIIa Factor X Activated protein. C Factor X Protein S Protein. C anticoagulant Tissue heparin antithrombin Factor Xa Factor Va Prothrombin

Normal Hemostasis Fibrinolytic system §High Molecular Weight Kininogen (HMWK) §Tissue plasminogen ac §Prekallekrein (PK) §Urokinase §F. XII Fibrin polymer Plasminogen Plasmin Fibrin degradation prod Streptokinase (FDP)

Normal Hemostasis “New concept !” Cell-based model of coagulation

Normal Hemostasis 1. Initiation IIa Hemostasis occurs on two surfaces: TF- bearing cells and platelet 2. Amplification 3. Propagation IIa

X prothrombin VIII/v. WF VIIIa TF VIIa X V a TF-expressing cell a IX thrombin. V VIIa TF IXa prothrombin XI Va XIa platelet IX XIa X IXa VIII a X V a a Activated platelet Hoffman M et al. Blood Coagul Fibrinolysis. 1998; 9(suppl 1): S 61 -S 65.

X prothrombin VIII/v. WF VIIIa TF VIIa X V a TF-expressing cell a IX thrombin. V VIIa TF IXa XI prothrombin Va XIa thrombin platelet IX XIa X IXa VIII a X V a a Activated platelet Hoffman M et al. Blood Coagul Fibrinolysis. 1998; 9(suppl 1): S 61 -S 65.

Cell-based model “Three overlapping phases” § Initiation phase “TF-bearing cell to generate F. Xa, F. IXa and (little amount of) thrombin” § Amplification phase “Gererate cofactor F. V and F. VIII by little amount of thrombin from initiation phase” § Propagation phase

Approach to Hemostatic Disorders: Clinical and Laboratory Approach Bundarika Suwanawiboon, M. D. Division of Hematology Department of Medicine

What is the diagnosis?

Clinical Evaluation of Bleeding Patients “ 80% of correct diagnosis can be made by history taking and physical examination. ”

History Taking Identify if the bleeding problem is due to Local vs. systemic defect Location: single vs. multiple sites Severity: Spontaneous? Appropriate to trauma? Hereditary vs. acquired disorder Onset Family history Underlying disease Medication Primary vs. secondary hemostatic disoder

Primary Hemostasis Secondary Hemostasis Onset Immediate Delayed Sites Skin Superficial Petechiae, superficial ecchymosis Mucosal Deep ecchymosis, hematoma Rare Common Others Rare Retroperitoneal hematoma, hemarthrosis

Primary Hemostatic defect Secondary Hemostatic defect

Laboratory Investigation of Hemostatic Disorders

Assessment of Primary Hemostasis Platelet Complete blood count (CBC) Bleeding time/ PFA-100 Platelet aggregation study Blood vessel Bleeding time von Willebrand factor (v. WF) Bleeding time v. WF Antigen, v. WF: RCO, v. WF multimer, FVIII

Complete Blood Count (CBC) Platelet number Normal platelet count: 150, 000 – 400, 000/u. L > 100, 000/u. L Bleeding unlikely < 20, 000/u. L ↑ risk for spontaneous bleeding Must exclude pseudothrombocytopenia Assess for platelet morphology
Thrombocytopenia Giant platelet Bernard-Soulier Syndrome Pseudothrombocytopenia

Etiology of Thrombocytopenia Decreased Production • Hypoproliferation • Aplastic Anemia, Amegakaryocytic thrombocytopenia, infection, toxins, drugs Infiltrative marrow disease, TAR • Ineffective Thrombopoiesis • Megaloblastic anemia Increased Destruction • Immune • Alloimmune, Autoimmune: ITP, SLE • Non-immune • DIC, TTP, HUS Others • Splenic sequestration • Hypersplenism • Dilutional • Massive blood transfusion

Bleeding Time

Bleeding Time: Interpretation Normal value* : 1 -9 min Prolonged bleeding time: Thrombocytopenia/ anemia (Hct < 20%) Hereditary platelet dysfunction von Willebrand disease Severe hypofibrinogenemia Blood vessels disorders Uremia Myeloproliferative disorders Medication: Aspirin, NSAIDs, other antiplatelet drugs

Platelet Aggregation Study

Normal Platelet Response Arterioscler Thromb Vasc Biol 2000 20: 285

Epinephrine ADP Collagen Ristocetin Arachidonic acid Normal Glanzmann’s +++ +++ +++ - - - +++ +++ - +++ + +* +* +++ ++ ++ - Thrombasthenia Bernard-Soulier Syndrome Storage Pool Disease Aspirin Effect (no secondary wave) + ++ +

von Willebrand Factor Synthesized in endothelial cells and megakaryocytes Two important functions: Carrier protein for plasma FVIII Ligand binding to platelet GPIb receptor to initiate platelet adhesion

Primary Hemostasis: v. WF Arterioscler Thromb Vasc Biol 2000 20: 285

von Willebrand Factor Panel v. WF antigen v. WF ristocetin cofactor activity v. WF multimer analysis FVIII level

v. WD Laboratory Diagnosis Test/Type 1 2 A N or ↑ ↑↑ v. WF: Ag ↓ ↓ v. WFR: Co ↓ LD-RIPA - BT 2 B 2 M 2 N ↑↑↑↑ ↓ ↓ or N ↓↓↓↓ ↓↓ ↓ ↓ or N ↓↓↓↓ - ↑ - - - N or ↑ 3 FVIII N or ↓ N ↓↓↓ Multimer N but ↓ abnormal N but ↓ absent

v. WF Multimer Analysis Hoffmann. 4 th Ed. Hematology Basic Principles and Practice

Assessment of Secondary Hemostasis Screening tests: PT a. PTT Mixing study Additional Tests Fibrinogen Thrombin Time Reptilase time Coagulation factor assays D-dimer Fibrin Degradation Product Euglobulin lysis time

Accurate Sample Collection is the Key Always use 3. 2% sodium citrate tube and sent to the lab immediately. Fill tube to the proper level. (anticoagulant to plasma ratio = 1: 9) Modification may be required based on Hct Sodium citrate (ml) = (100 – Hct pt) x 0. 5 / 55* * normal plasma vol.

Extrinsic Pathway Intrinsic Pathway XII TF XIIa XI HK/PK HMWK XIa VIIa Tenase IX IX IXa/ IXa VIIIa/PL VIIIa X X VIIa/TF Xa Xa Ca++ II II Ca++ IIa Va/PL Fibrinogen Common Pathway Fibrin XIIIa X-linked. Fibrin

Prothrombin Time (PT) PT : test extrinsic and common pathway

Activated Partial Thromboplastin Time (a. PTT) a. PTT : test intrinsic and common pathway

Mixing Study Deficiency Correctable Normal coagulation time 50% + Inhibitor 0% 100% Prolonged PT or a. PTT occurs when coagulation factor < 35 -40% <35% Uncorrectable prolonged coagulation time

Interpretation of Abnormal Coagulogram Isolated prolonged PT Isolated prolonaged a. PTT Prolonged PT and a. PTT

Isolated prolonged PT Mixing study Correctable Deficiency Hereditary: FVII Acquired: Early liver impairment Vitamin K antagonist Vitamin K deficiency Uncorrectable Inhibitor FVII (rare) Lupus anticoagulant

Isolated prolonged a. PTT Bleeding No bleeding Mixing study Correctable Uncorrectable Deficiency Inhibitor Factor VIII /v. WD Factor IX Factor XI t Factor VIII Factor IX Factor XI Heparin Factor XII HMWK Prekallekrein Lupus anticoagulan

Acquired FVIII inhibitor

Prolonged a. PTT and PT Mixing study Correctable - FII, FV or FX deficiency - FV and VIII deficiency - Liver disease - Vitamin K antagonist - Vitamin K deficiency - DIC Uncorrectable - FII, V, or X inhibitor - Lupus anticoagulant - LAC + Factor inhibitor

Bleeding Disorders with Normal PT and a. PTT Factor XIII deficiency Dysfibrinogenemia Mild isolated factor deficiency a 2 -antiplasmin deficiency Elevated fibrin degradation products Platelet disorders Vascular disorders

Further Diagnostic Tests Specific coagulation factor assay Coagulation factor inhibitor assay Lupus anticoagulant panel

Other Tests for Secondary Hemostasis Fibrinogen D-dimer Fibrin(ogen) degradtion product Thrombin time Reptilase time Euglobulin lysis time

Fibrinogen Functional level (200 -400 mg/dl) ↓ Fibrinogen (esp. < 100 ) DIC Fibrinolytic therapy Primary fibrinolytic state Congenital afibrinogenemia Acquired/congenital dysfibrinogenemia ↑ Fibrinogen Inflammatory states/acute illness May associated with shortened PT/a. PTT

D-Dimer Measured cross-linked fibrin degradation product by plasmin More sensitive and specific for fibrinolysis than Fibrin(ogen) Degradatioin Product (FDP) ↑ D-dimer: DIC Acute thromboembolic episodes Post-trauma or surgery Malignancy

Fibrin(ogen) Degradation Product ↑ levels in Primary fibrinolytic syndromes DIC After lytic therapy Acute thromboembolic episodes After injury/surgery

Thrombin Time (TT) – Assess the ability to convert fibrinogen fibrin by adding thrombin to plasma Prolonged TT: – Inhibitor of thrombin: heparin, anti-thrombin antibody – Hypofibrinogenemia or dysfibrinogenemia – Inhibitor of fibrin polymerization: fibrin degradation product, paraprotein

Euglobulin Lysis Time Euglobulin fraction of plasma is precipitated by acetic acid and thrombin added. Lysis of clot is observed. Normal : > 120 min Shortened ELT: DIC Liver disease Primary fibrinogenolysis: malignancy, e. g. prostate carcinoma


Management of Bleeding Patients Yingyong Chinthammitr 27 June 2007

Objectives • Efficient practice of replacement therapy • Management of common bleeding problems

Goal of replacement Rx • Treatment of bleeding • Prevention of bleeding before procedure • Not treat only lab. esp. in irreversible causes of coagulopathy

1 unit WB = Whole blood WB PRC PRP FFP CRP PC Cryo PRC = Pack Red Cell PRP = Platelet-rich plasma FFP = Fresh frozen plasma PC = Platelet concentrates (other: apheresis PLT = 4 -6 u) CRP = Cryo-removed plasma, FFP with cryo. -removed Cryo. = Cryoprecipitate )F VIII 100 u, v. WF, Fibrinogen, F XIII(

Other products • • Factor concentrates : VIII, IX Prothrombin complex concentrates (PCC) Activated PCC (APCC) DDAVP Vitamin K injection Recombinant F VIIa (novoseven) Tranexamic acid – antifibrinolysis Fibrin glue – two bottles: Fibrinogen & Thrombin

Recombinant Factor VIIa (Novoseven. R( EFFECTIVE+SAFE but VERY EXPENSIVE -Hemophilia with inhibitor (alloantibody( -Factor VIII inhibitor (autoantibody( -Uncontrolled bleeding from coagulopathy (liver failure( -Uncontrolled bleeding from thrombocytopenia -Uncontrolled bleeding from platelet dysfunction (uremia , congenital defect( -Severe surgical and traumatic hemorrhage

II X TFPI Xa VIIa TF TF Xa VIII/v. WF IIa Va Platelet V V Tissue factor--bearing cell IX IX T TF TF F VIIa XI a X Va II IXa VIIIa Activated platelet Xa Va. Va VIIIa + free v. WF IIa XI XIa

II X TFPI Xa VIIa TF TF Xa VIII/v. WF IIa Va Platelet V V Tissue factor--bearing cell T TF TF F VIIa X Va II Xa Activated platelet Va. Va VIIIa + free v. WF IIa XI XIa

Fibrin Glue -ม 2 ขวด คอ . 1 Thrombin 2. Fibrinogen, F XIII (cryoprecipitate) Thrombin XIIIa Fibrinogen ------->Fibrin ------> Cross-linked Fibrin เตม Calcium ใน Thrombin อาจเตม Tranexamic acid ใน Fibrinogen ใช อปกรณ two syringes with one air-line

Tranexamic acid -anti-fibrinolysis -adjunctive Rx in areas with high fibrinolysis (Oral cavity, GI tract, GU tract( -Contraindication : DIC, Thrombosis, Renal bleeding (obstructive uropathy( -IV : 10 mg/kg/dose q 8 h -Oral : 25 mg/kg/dose q 8 hr -Oral wash in dental bleeding

Bleeding • Thrombocytopenia • Coagulopathy • Combined

Platelet level & Bleeding • • • /100, 000 <mm 3 /100, 000 >mm 3 /50, 000 >mm 3 /10, 000 >mm 3 /5, 000 >mm 3 No bleeding tendency Bleeding time prolongation Bleeding after trauma , surgery Spontaneous bleeding High risk for spontaneous CNS bleeding

Thrombocytopenia & Bleeding • • • Platelet level Platelet function Anemia Local problem Coexisting coagulopathy

Platelet transfusion • Symptomatic Rx , not Rx cause • Dose: 1 unit per 10 kg BW • Indication – Bleeding associated with thrombocytopenia – Prophylaxis, before invasive procedure/surgery • Contra-indication – TTP (Thrombotic thrombocytopenic purpura) /HUS (Hemolytic uremic syndrome), HIT (Heparin-induced thrombocytopenia)

Prophylaxis in thrombocytopenia Condition Threshold Chronic stable thrombocytopenia <5, 000 or (underproduction e. g. aplastic anemia) No Post-chemo stable patient <10, 000 Unstable (fever or infection or coagulopathy or platelet dysfunction) <20, 000 Invasive procedures, surgery <50, 000 Neurosurgery, ocular Sx <100, 000

Plasma derivatives: FFP, Cryo. • No medications added • Return to blood bank if not use within 30 min • Most adverse transfusion reactions occur in the first 15 min. • Time of transfusion – not exceed 4 hr • Rate in adult (good cardiac condition) : 200 - 300 m. L/hr • NOT for: volume expansion, protein (alb, glob) nutrient

Cirrhosis • FFP 10 -15 ml/kg • Vitamin K 10 mg IV • Pitfalls – Uncorrected localized bleeding problem e. g. varice, mucosal lesion – Overdependence on PT – Goal: to correct or prevent bleeding, Not to achieve a normal PT – Timing of FFP therapy before an invasive procedure

Vitamin K deficiency -Vitamin K : fat-soluble vitamin - Vitamin K-dependent factors : II, VII, IX, X ; Protein C, S, Z - Vit. K : K 1(green vegetables), K 2(gut flora), K 3(synthetic water-soluble(

Vitamin K deficiency *Neonatal : hemorrhagic disease of the newborn * Children & Adult : - low intake - absorption defect - cholestasis, fat malabsorption syndrome - broad-spectrum antibiotics (+low intake(

Vitamin K deficiency • Vit. K 10 mg IV slowly, sc • FFP • Prothrombin complex concentrate (PCC)

HEMARTHROSIS AND HEMOPHILIC ARTHROPATHY

Hemophilia A • Cryoprecipitate • Factor VIII concentrates • FFP • DDAVP v. WD • DDAVP • Cryoprecipitate • F VIII concentrates • FFP Hemophilia B • FFP • Cryo. Removed Plasma • F IX concentrates

Rx of Bleeding episodes in Hemophilia Site Level (%) Rx Length Joint 30 -40 1 dose Muscle 30 -40 1 -3 doses Hematuria 30 -40 1 dose Retroperitoneal 50 5 -7 d GI 50 5 -7 d Neck 100 7 -10 d Intracranial 100 10 -14 d

Hemophilia A with hemarthrosis • • 60 kg. Raise F VIII to 30 % 1 u/kg raise 2% F VIII half life = 12 hr – Raise 30% -> 15 u/kg = 15 x 60 = 900 u – Cryo. 9 bags ( cont. ~5 bags q 12 hr)

Hemophilia B with hemarthrosis • • 60 kg. Raise F IX to 30 % 1 u/kg raise 1% F IX half life = 24 hr – Raise 30% -> 30 u/kg = 30 x 60 = 1800 u – FFP 1800 ml. ( cont. 900 ml. q 24 hr)

Warfarin-associated coagulopathy & bleeding • Life-threatening Bleeding – withhold warfarin, FFP/PCCs, vit. K 5 -10 mg. i. v. , provide medical support (e. g. PRC) • Major, non-life-threatening Bleeding – withhold warfarin, FFP/PCCs, vit. K 1 -10 mg. i. v. , provide medical support (e. g. PRC) J Thromb Haemost 2006; 4: 1853 -63

Warfarin-associated coagulopathy & No bleeding INR 4. 5 -10 – Withhold warfarin – Vit. K 1 mg. – Reintroduce at a – Recheck INR in 24 -48 hr lower dose on the following day – Recheck INR in < 72 hr INR >10 – Withhold warfarin – Vit. K 1 mg. i. v. – Recheck INR in 24 hr Identify and correct the cause of elevated INR Beware of re-thrombosis from overcorrection J Thromb Haemost 2006; 4: 1853 -63

Heparin • Unfractionated heparin (prolonged APTT) – Bleeding: hold heparin, protamine (1 mg/100 u heparin) – No bleeding: hold heparin (Hf. life 1 hr) • LMWH (normal APTT) – Bleeding: protamine (neutralize all anti-IIa but 75% of anti-Xa)

DIC • Rx cause • Bleeding – FFP , PLT concentrate – Cryoprecipitate raise fibrinogen > 100 mg/d. L : 1 bag/5 kg BW raise fibrinogen 100 mg/d. L

Treatment of DIC * Treat associated disease * Bleeding - Replacement therapy * Thrombosis - heparin : purpura fulminans, acral/dermal ischemia, retained dead fetus syndrome, giant hemangioma, aortic aneurysm without rupture, solid tumor * AT concentrate, APC

Massive blood transfusion • > Total blood volume in 24 hour • Dilution and/or consumption of PLT, Coag. Factors • LAB: platelet, coagulogram, fibrinogen • PLT > 50, 000, PT <1. 5 times the midpoint of normal range, Fibrinogen >100 mg/d. L : generally adequate for hemostasis

Platelet dysfunction • Stop Antiplatelet agents before surgery – Aspirin : 7 days (irreversible inhibition) – NSAID : 1 -4 days (reversible inhibition) – Clopidogrel : 10 days

Uremic bleeding Treatment Regimen Onset *PRC /LPB Hct ~30% 1 h *EPO 50 -100 U/kg Hct 30% (~6 wk) *Cryoppt. 10 units 1 h *DDAVP 0. 3 -0. 4 mcg/kg 1 h IV or SC 2 -3 mcg/kg intranasal *Conjugated 0. 6 mkd IV 6 h estrogen 50 mkd po 2 d x 5 days *Dialysis Duration While Hct at this level Same 24– 36 h[Effective ~ 50%] 4– 8 h 14 d (IV) 5 d (PO)

Thank you for your attention Question…
8321d93801848b58458bc2346bb0b602.ppt